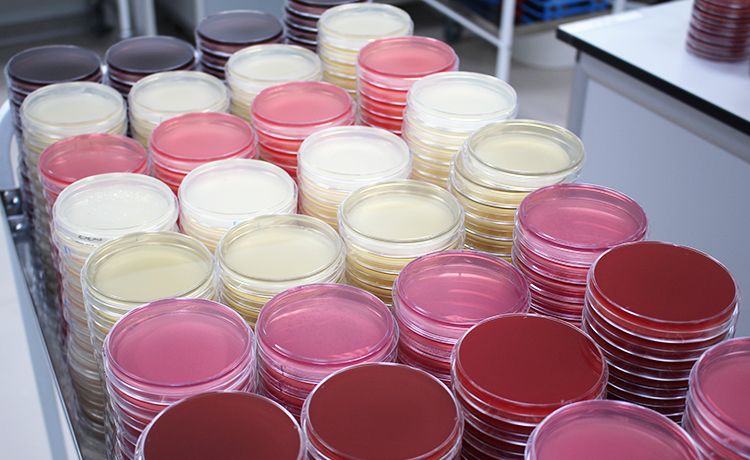

Анализ показателей дисбактериоза: что важно знать
























.png)

Раздел: Фотомозаика мудрости